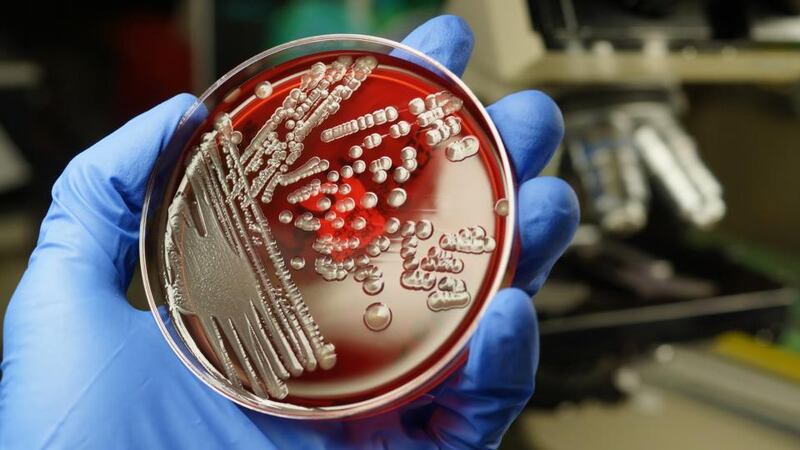

While abortion legislation has been the subject of the discussion in the wake of the death of Savita Halapanavar, little attention has been given to ESBL – the antibiotic-resistant infection from which she suffered.
Evidence throughout Europe now frames ESBL bacteria (extended-spectrum ß-lactamases) as a significant threat to human health and its rising prevalence could be linked to foods we eat.
Hospital bugs such as MRSA and C.difficile have dominated discussion in Ireland but ESBL is a more dangerous operator and rising in populations year on year.
If you are a carrier of these E.coli – and it’s estimated that about 6 per cent of the Irish population are carriers – then small illnesses like urinary tract infections (UTIs) can not only be difficult to treat, but could entail a stay in hospital and, at worst, as European clinicians are finding, lead to fatal outcomes.
In Holland, unusual levels of young girls and elderly women dying from UTI infections led Prof Jan Klutymans to survey if E.coli resistant bacteria could be passing from poultry faeces in intensive farming into the human population via chicken meat bought by consumers.
His results, published in the journal Emerging Infectious Diseases , were alarming. Isolating E.coli from patients in four Dutch hospitals, Klutymans compared the results to E.coli taken from randomly chosen supermarket chicken samples bought in the hospitals' local areas.
Some 94 per cent of the Dutch retail meat samples contained ESBL-producing isolates of which 39 per cent belonged to E.coli genotypes also present in human samples. The research suggested that the transmission of ESBL genes from poultry to humans came most likely via the food chain.
Antibiotics in animals
Feeding of antibiotics to housed animals in Europe has been a recognised problem in bacterial resistance in human health. Its links to public health in Holland has led to new targets being established to cut the rate of antibiotics fed to animals in the food chain. If you are a chicken or pig meat farmer, you cannot enter a Dutch hospital without a "decontamination period" away from other patients.
Antibiotics fed to animals are often very similar or identical in class to ones in human use. In the guts of pigs, chickens and bovines, bacteria grows resistance to these drugs. Entering the human population, the same drugs are administered with increasingly little effect.
is already with us, and more difficult to prevent or contain than MRSA or C. difficile ".
Recently, evidence shows that as ESBL- producing bacteria grow in numbers, the “reserve” list of antibiotics are being used more frequently, with the result that new resistances are developing.
Zoonotic diseases
In 2011 the European Food Safety Authority compiled a report on antimicrobial resistance in zoonotic bacteria such as ESBL affecting humans, animals and food.
Zoonotic diseases are ones which pass between animal and human populations and have been recognised for many centuries.
Over 200 have been described including Aids, BSE and brucelloisis. Caused by many types of agents such as parasites, viruses and bacteria, the WHO states that the current upwards trend for emerging zoonotic diseases is likely to continue.
In 2006 EU legislation banned the use of antibiotics used for growth promotion in animal feed. But countries like Holland still top the table of antibiotics fed to farm animals.
In Ireland, data is difficult to collect with no figures available from the Department of Agriculture on the amount or class of antibiotics fed to Irish animals entering the food chain. Holland has a vigilant public health policy now in place to monitor the rise of ESBL. Are we taking the problem seriously enough in Ireland?
"This is a huge issue, antibiotics both in veterinary medicine and in hospital environments create selective pressure and these organisms are adapting" says Seamus Fanning, professor of food safety and zoonoses in UCD who is working with a Swiss team of researchers on identifying ESBL genes in the gut of food animals and in other organisms.
“In Ireland we don’t have a lot of data but we need this information and we need it urgently, this is far more important to our health than something like horsemeat in the food chain.”
Liberalisation of antibiotics in human medicine in Asia has meant very high rates of ESBL in patients in India and Thailand, where you can buy antibiotics over the counter. “In some jurisdictions the availability of antibiotics has placed more pressure in these areas and so we see higher levels of ESBL in populations there,” says Prof Fanning.
“In Ireland the regimes are less liberal in human medicine but we need Government action to bring together all the agents; from the human and animal medicine to find where the repositories of ESBL are, and to take action.”









